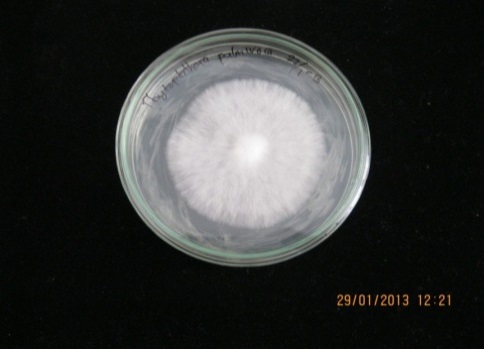

Int J Pharm Pharm Sci, Vol 7, Issue 7, 325-328Original Article
ANTIFUNGAL PHYTOPHTHORA PALMIVORA FROM CLOVE BUDS (SYZYGIUM AROMATICUM L.)
DIAH LIA AULIFA1,3, I NYOMAN PUGEG ARYANTHA2, SUKRASNO1
1Pharmaceutical Biology Research Group, School of Pharmacy, Bandung Institute of Technology, Indonesia, 2School of Biological Science and Technology,Bandung Institute of Technology, Indonesia, 3Indonesian School of Pharmacy, Indonesia
Email: diahliaaulifa@gmail.com
Received: 09 Mar 2015 Revised and Accepted: 30 May 2015
ABSTRACT
Objective: Clove buds (Syzygiumaromaticum) have been reported as a natural fungicide and could be an alternative fungicide for Phytophthorapalmivora one of pathogenic fungi in Cacao plantations. The aim of this research was to evaluate an antifungal Phytophthora of the essential oil, extract, fraction, bioactive compounds from clove buds.
Methods: Successive extractions of clove buds were performed by maceration with n-hexane, ethyl acetate and methanol. Fractionation and purification were performed using vacuum liquid chromatography and column chromatography. Identification of the isolated compounds was performed by thin layer chromatography (TLC), gas chromatography (GC) and gas chromatography-mass spectrometry (GC-MS). Agar well diffusion method was used as the assay method and then the percentage radial growth inhibition of Phytophthoramy celium was calculated on the fifth days.
Results: At 10 mg/ml, the n-hexane extract showed the highest inhibition 90.00 %, followed by ethyl acetate extract, essential oil and methanol extract with 78.00 %, 72.72 %, and 29.17 % inhibition, respectively. Two active fractions from vacuum liquid chromatography (VLC) of n-hexane extract were obtained with 49.29 % (F-2), and 90.00 % (F-5) inhibition, respectively at 5 mg/ml. Two active subfractions were obtained from column chromatography with inhibition 8.79 % (F-A) and 89.01 % (F-B), at 5 mg/ml. The thin layer chromatography (TLC) and gas chromatography (GC) showed that F-B consists of one of a compound having the same Rf and Rt values that of a eugenolauthentic marker. The gas chromatography-mass spectrometry (GC-MS) data showed that the major compound in F-A was caryophyllene (M 204), and F-B was eugenol (F-B1) (M 164) and acetyl eugenol (F-B2) (M 206).
Conclusion: Eugenol and eugenol acetate were the main active compounds effective in inhibiting as antifungal P. palmivora.
Keywords: Syzygiumaromaticum, Eugenol, Phytophthorapalmivora, Agar well diffusion.
INTRODUCTION
Plant fungal diseases pose the serious problem in agriculture and contribute significant losses of agricultural products [1]. In 1840s, Phytophthorainfestans (Mont.) de Bary was responsible for the Irish potato famine which caused the potato late blight epidemic. In the short term, fungal plant diseases caused economic losses to growers, increase prices of produce to consumers and also have direct pathological effects on humans and animal [2]. Another species, Phytophthora palmivora not only known as pathogenic fungal which caused black pods in cocoa, but also fruit rots, stem cankers, leaf and seedling blights, root rots of tropical plants and other important horticultural hosts [3]. Control of plants fungal infection has been conducted by toxic fungicide are utilized each year and the agents used may pollute water and terrestrial environments or long period [2]. Although effective, it has disrupted natural biological control system and may develop resistance, gives undesirable effects on non target organisms [4, 6]. Hence, there is a great demand for novel antifungals that selectively acting on new targets but less side effect. Plant metabolites, either pure compound or standardized extract might be potential as the source for drug development in pharmaceutical or agricultural sectors [1]. Crude drugs, extract, and essential oil have been used as natural antifungal agent [7, 8]. Syzygiumaromaticum or clove oil and extract were found to possess a strong antifungal activity against phatogenic fungi Phytophthorasp, Fusarium sp., Aspergillus sp., Coletrotichum sp [6, 7, 9]. Indonesia is one of the major Asian producers of Syzygiumaromaticum (clove) besides Malaysia, Sri lanka and India [10]. Comparison with extracts of 10 potential fungicide crude drugs showed that the clove buds extract possesed the highest antifungal activity [9]. In this research, we conducted isolation of active antifungal Phytophthora through extract and fraction guided antifungal test. Therefore, it will be potential to develop natural fungicide from S. aromaticum. The aim of this study was to evaluate the use of clove oil, extracts, fractions and its major compounds of that contribute to the antifungal Phytophthora activity.
MATERIALS AND METHODS
Plant material
Clove buds (S. aromaticum) were collected from Garut, West Java, Indonesia. Taxonomic determination was conducted at the Herbarium Bandungense, ITB, Bandung-West Java. The plant materials were dried in a drying cabinet at 40-50 °C, then ground to powder.
Organism and growth media
P. palmivora, was obtained from the collection of Mycology laboratory, the Centre of Life Sciences, ITB, Bandung. P. palmivora was maintained on Potato Dextrose Agar (PDA) for 7 d at room temperature (25-30 °C).
General experimental apparatus
Identification of the active compounds was determined mainly by Gas Chromatography-Mass Spectrometry (GC-MS) with column BD5, column temperaturestart from 60 °C then increase 8 °C per min until reachingtemperature 280 °C, detector temperature 290 °C, injector temperature 270 °C, flow rate 1.32 ml/min (Shimadzu QP 2010 ULTRA).
Extraction and fractionation
Clove buds powder (500 g) was macerated successively at room temperature using n-hexane, ethylacetate and methanol (4 l) for3x24hrespectively. Each extract was evaporated using arotary evaporator at 50oC. Isolation of clove oil was performed by steam distillation using 40 gclove powders. The extract and clove oilwere tested for the antifungal activity. Analytical Thin-Layer Chromatography (TLC) was performed on precoated silica gel 60 GF254 plate (Merck). The spots of each extract and the essential oil were compared with eugenolauthentic marker (Sigma-Aldrich) and visualized under UV light and by spraying with p-anisaldehide-sulfuric acid reagent. The n-hexane extract (20 g) was separated on vacuum liquid chromatography (13 x 10 cm); packed with 200 g Kiesel gel 60 H, 10-40 µm mesh (Merck), eluted with gradient elution using a combination of n-hexane and ethyl acetate to give seven fractions named F1-F7. Each fraction was tested for the antifungal activity.
Fraction F2 was chromatographed on column (2.0 x 45 cm) packed with 25 g Kiesel gel 60 (Merck), eluted withn-hexane to give eight fractions named F2A-F2G. Fraction F2A was further chromatographed on column (2.0 x 45 cm) packed with 20 g Kiesel gel 60 (Merck) eluted with n-hexane to give nine sub fractions named F2A. A-F2A. I. Fraction F2A. E was chromatographed on column (2.0 x 45 cm) packed with 15 g Kiesel gel 60 (Merck) eluted withn-hexane to give ten sub fractions named F2A. E1-F2A. E10. Each sub fraction was tested for antifungal activity. Fraction F5 was separated on vacuum liquid chromatography (9 x 17 cm) packed with 100 g Kiesel gel 60 H (Merck) eluted with n-hexane and ethyl acetate to give seven fractions named F5A-F5G. Fraction F5Ewas chromatographed on the column (2.0 x 45 cm) packed with 30 g Kiesel gel 60 (Merck) eluted n-hexane and ethyl acetate to give eight sub fractions named F5E.1-F5E.8. Each subfraction was tested for the antifungal activity.
Antifungal activity
Antifungal activity assays was performed using the agar well diffusion method. This method was done by pouring 15 mlPDA medium into Petri dishes with diameter 9 cm. After PDA medium solidified, four holes were made and 50 µl extract applied to each hole. The P. palmivoramy celium diameter 5 mm was placed in the middle of Petri dish, and then incubated at 25-30 °C for 5d[8,11].
The antifungal activity was presented in% inhibition of mycelium growth and calculated according to the following equation:

Note: a = control mycelium diameter (mm)
b = sample mycelium diameter (mm)
The antifungal activity was shown by inhibition of mycelial growth by compounds diffused into the media as shown in fig. 1.
 |
|
| A | B |
Fig. 1: Phytophthora palmivora mycelium growth with the presence of clove buds extract 50 µl/hole (A) and control P. palmivora after 5 d inoculation (B)
RESULTS
Antifungal activities of extract, fraction and sub fraction from clove buds
Succesive extraction of 500 g clove powder produced 92.66 g hexane extract, 23.74g ethyl acetate extract and 70.55 g methanol extract. Among the three extracts and clove oil, the n-hexane extract showed the highest antifungal activity, followed by ethyl acetate extract, clove oil and methanol extract with 90.00 %, 78.00%, 72.72 %, and 29.17 % inhibition respectively against P. palmivora at 10 mg/ml (table 1).
Table 1: The antifungal activities from clove buds
| Sample | Concentration (mg/ml) |
| 10 | |
| n-hexane extract | ++++ |
| Ethyl acetate extract | ++++ |
| Methanol extract | ++ |
| Clove oil | +++ |
-: no activity,+: activity 1-25 %,++: activity 26-50 %,+++: activity 51-75 %,++++: activity 76-100 %
Further work needs to be performed to investigate the component that responsible to give antifungal activity. Among the seven fractions that were collected from n-hexane extract, the fraction F2 and F5 were found to be abundant, and the five other compounds were only in limited quantities. Therefore, only 2 fractions were tested for their antifungal activities. FractionF2 (2.03 g) showed moderate antifungal activity (less than 50 % inhibition) while fraction F5 (14.87 g) showed high antifungal activity (more than 76 % inhibition) at 2.5 mg/ml (table 2).
Table 2: The antifungal activities from active fraction
| Sample | Concentration (mg/ml) |
| 5 | |
| Fraction F2 | ++ |
| Fraction F5 | ++++ |
-: no activity,+: activity 1-25 %,++: activity 26-50 %,+++: activity 51-75 %,++++: activity 76-100 %
Table 3: The antifungal activities from active sub fraction
| Sample | Concentration (mg/ml) |
| 5 | |
| Sub fraction F-A | + |
| Sub fraction F-B | ++++ |
-: no activity,+: activity 1-25 %,++: activity 26-50 %,+++: activity 51-75 %,++++: activity 76-100 %
Isolation and identification of antifungal compounds from S. aromaticum
Active fraction was continued with isolation to obtain compounds that have activity against Phytophthora. Fraction F2 produced an active subfraction F2A. E7and fraction F5 gave active sub fraction F5E.6. Sub fraction F2A. E7, was named as F-A, showed weak antifungal activity at 2.5 mg/ml, whereas sub fraction F5E.6, was named as F-B, showed the strongest antifungal activity at 2.5 mg/ml, it still has more than 80 % inhibition of mycelia growth against Phytophthora (table 3).
Characterization of sub fraction
Sub fraction F-A
Sub fraction F-A, collected from fraction F2, was clear and aromatic oil. It was predicted as components of clove oil, based on TLC chromatogram compared with the clove oil (purchased from Manoko, West Java, Indonesia). The subfraction F-A gave pink spot with Rf value 0.85 using n-hexane-ethyl acetate (9:1) and anisaldehide-sulfuricacid as spray reagent. The chromatogram of gas chromatography showed the main peak (F-A) the major component at 80.52% based on the peak area and few minor peaks. The main peak F-A (fig. 3) has retention time 12 minutes with m/z 133 [M+] 204 in EI-MSwithamolecular formula C15H24and identified as caryophyllene (bicyclic sesquiterpene).

Fig. 2: GC-MS chromatogram major peak of sub fraction F-A (caryophyllene)
Sub fraction F-B
Sub fraction F-Bwas collected from fraction F5. It was clear, pale yellow, aromatic, leaved warm in hand. One of the components was identified as eugenol after comparison with eugenolauthentic marker (Sigma-Aldrich). The Rf value was 0.35 on TLC using (n-hexane-ethyl acetate (9:1) as solvent and anisaldehide-sulfuric acid as spray reagent. Analysis by GC-FID gave two main peaks F-B1 and F-B2 (fig. 3). The peak F-B1 has retention time 13.7 minutes, same with eugenolauthentic marker while F-B2 at 11 minutes. The peak F-B1 has m/z 164, [M+] in EI-MS with a molecular formula C10H12O2 and identified as eugenol. The peak F-B2 has m/z 206, [M+] in EI-MS with a molecular formula C12H14O3and identified as acetyl eugenol.


Fig. 3: GC-MS chromatogram major peak of sub fraction F-B1 (eugenol) and F-B2 (eugenol acetate)
These results concluded that eugenol and eugenol acetate were the compounds that contribute in theinhibition mycelium of Phytophthora.
DISCUSSION
It seems that n-hexane extract was more effective than the volatile oil. Although the major content of the clove oil was eugenol(80-90%), but the n-hexane extract gave the highest activity. This way is due to the resultant effect of eugenol and other minor component that also has antifungal activity. It indicated that the n-hexane extract contains compounds that work synergistically with each other. This is also supported with the fact that the extraction with hexane produced higher yield compared to the oil yield after a steam distillation. If it is intended as bio fungicidal it would better to use the n-hexane extract than the oil due to higher activity.
It is interesting that the main active compound antifungal Phytophthora was eugenol (natural phenolic) that constitute as the major compound of clove oil or its n-hexane extract. The structures of the phenolic compounds,not only can diffuse through the microbial membrane,but also penetrate into inside cell, where they can interfere in the metabolic pathways by interfering with the biosynthesis of ergosterol and proteins in fungi cell[12]. Another research, eugenol can inhibited the growth of fungal mycelia, but eugenol was not effective in preventing germination while the growth of conidia germination is the growth stage most sensitive to inhibition many compounds [13]. In recent years, given its low toxicity and less residual activity, clove bud has been widely used in agricultural but still not yet integrated with industrial production [14].
CONCLUSION
In conclusion, clove buds (S. aromaticum) could be potential as an alternative source to produce natural fungicides. N-hexaneextract, fraction and sub fraction were efficiently suppressed mycelial growth. Therefore the oil or the extract can be used directly as an active agent for natural fungicide. Eugenol (F-B1)and acetyl eugenol (F-B2) were the main responsible compounds for antifungalactivity. Caryophylene as the major component of sub fractionF-A,has weak activity against P. palmivora.
ACKNOWLEDGEMENT
We would like to thank to the IM-HERE Research Fund 2012 of School of Pharmacy, Bandung Institute of Technology for funding and supporting on this research.
CONFLICT OF INTERESTS
The authors have no conflict of interest directly relevant to the content of this article
REFERENCES
- Sati SC, Joshi S. Aspects of antifungal potential of etnobotanically known medicinal plants. Res J Med Plant 2011;5(4):377-91.
- Yulia E. Antifungal activity of plant extracts and oils against fungal pathogens of pepper (Piper nigrum L.), cinnamon (Cinnamomum zeylanicum Blume.), and turmeric (Curcuma domestica Val.). Thesis James Cook University. Australia; 2005.
- Kroon, LPNM, Brouwer H, de Cock AWAM, Govers F. The Genus Phytophthoraanno. Phytopathology 2012;102:348-64.
- Lee H, Choi K, Cho K, Ahn Y. Fungicidal activity of ar-turmerone identified in curcuma longa rhizome against six phytopathogenic fungi. J Agric Food Chem 2003;46(1):25-8.
- Kim E, Park IK. Fumigant antifungal activity of Myrtaceae essential oils and constituents from Leptospermum petersonii against three Aspergillus species. Molecules 2012;17(9):10459-69.
- Yazdani D, Tan YH, Zam A, Jaganath IB. A review on bioactive compounds isolated from plants against plant pathogenic fungi. J Med Plants Res 2011;5(30):6584-9.
- Rana IS, Rana AS, Rajak RC. Evaluation of antifungal activity in essential oil of the Syzygium aromaticum (L.) by extraction, purification and analysis of its main component eugenol. Braz J Microbiol 2011;42(4):1269-77.
- Park M, Gwak K, Yang I, Choi W, Jo H, Chang J. Antifungal activities of the essential oils in Syzygium aromaticum (L.) Merr. Et Perry and Leptospermum petersonii bailey and their constituents against various dermatophytes. J Microbiol 2007;45(5):460-5.
- Aulifa DL, Aryantha INP, Sukrasno. Aktivitas antijamur ekstrak metanol dari tumbuhan rempah-rempahan. J Bionatura 2014;16(1):12-8.
- Kamatou GP, Vermaak I, Viljoen AM. Eugenol-from the remote maluku islands to the international market place: a review of a remarkable and versatile molecule. Molecules 2012;17(6):6953-81.
- Wuthi-udomlert M, Kupittayanant P, Gritsanapan W. In vitro evaluation of antifungal activity of anthraquinone derivatives of Senna allata. J Heal Res 2010;24(3):117-22.
- Ansari M, Anurag A, Fatima Z, Hameed S. Natural phenolic compounds: a potential antifungal agent. Microb Pathog Strateg Combat them Sci Technol Educ. 2013;1:1189-95.
- Wang C, Zhang J, Chen H, Fan Y, Shi Z. Antifungal activity of eugenol against Botrytis cinerea. Trop Plant Pathol 2010;35:137-43.
- Kong X, Liu X, Li J, Yang Y. Advances in pharmacological research of eugenol. Curr Opin Complement Altern Med 2014;1(1):8-11.